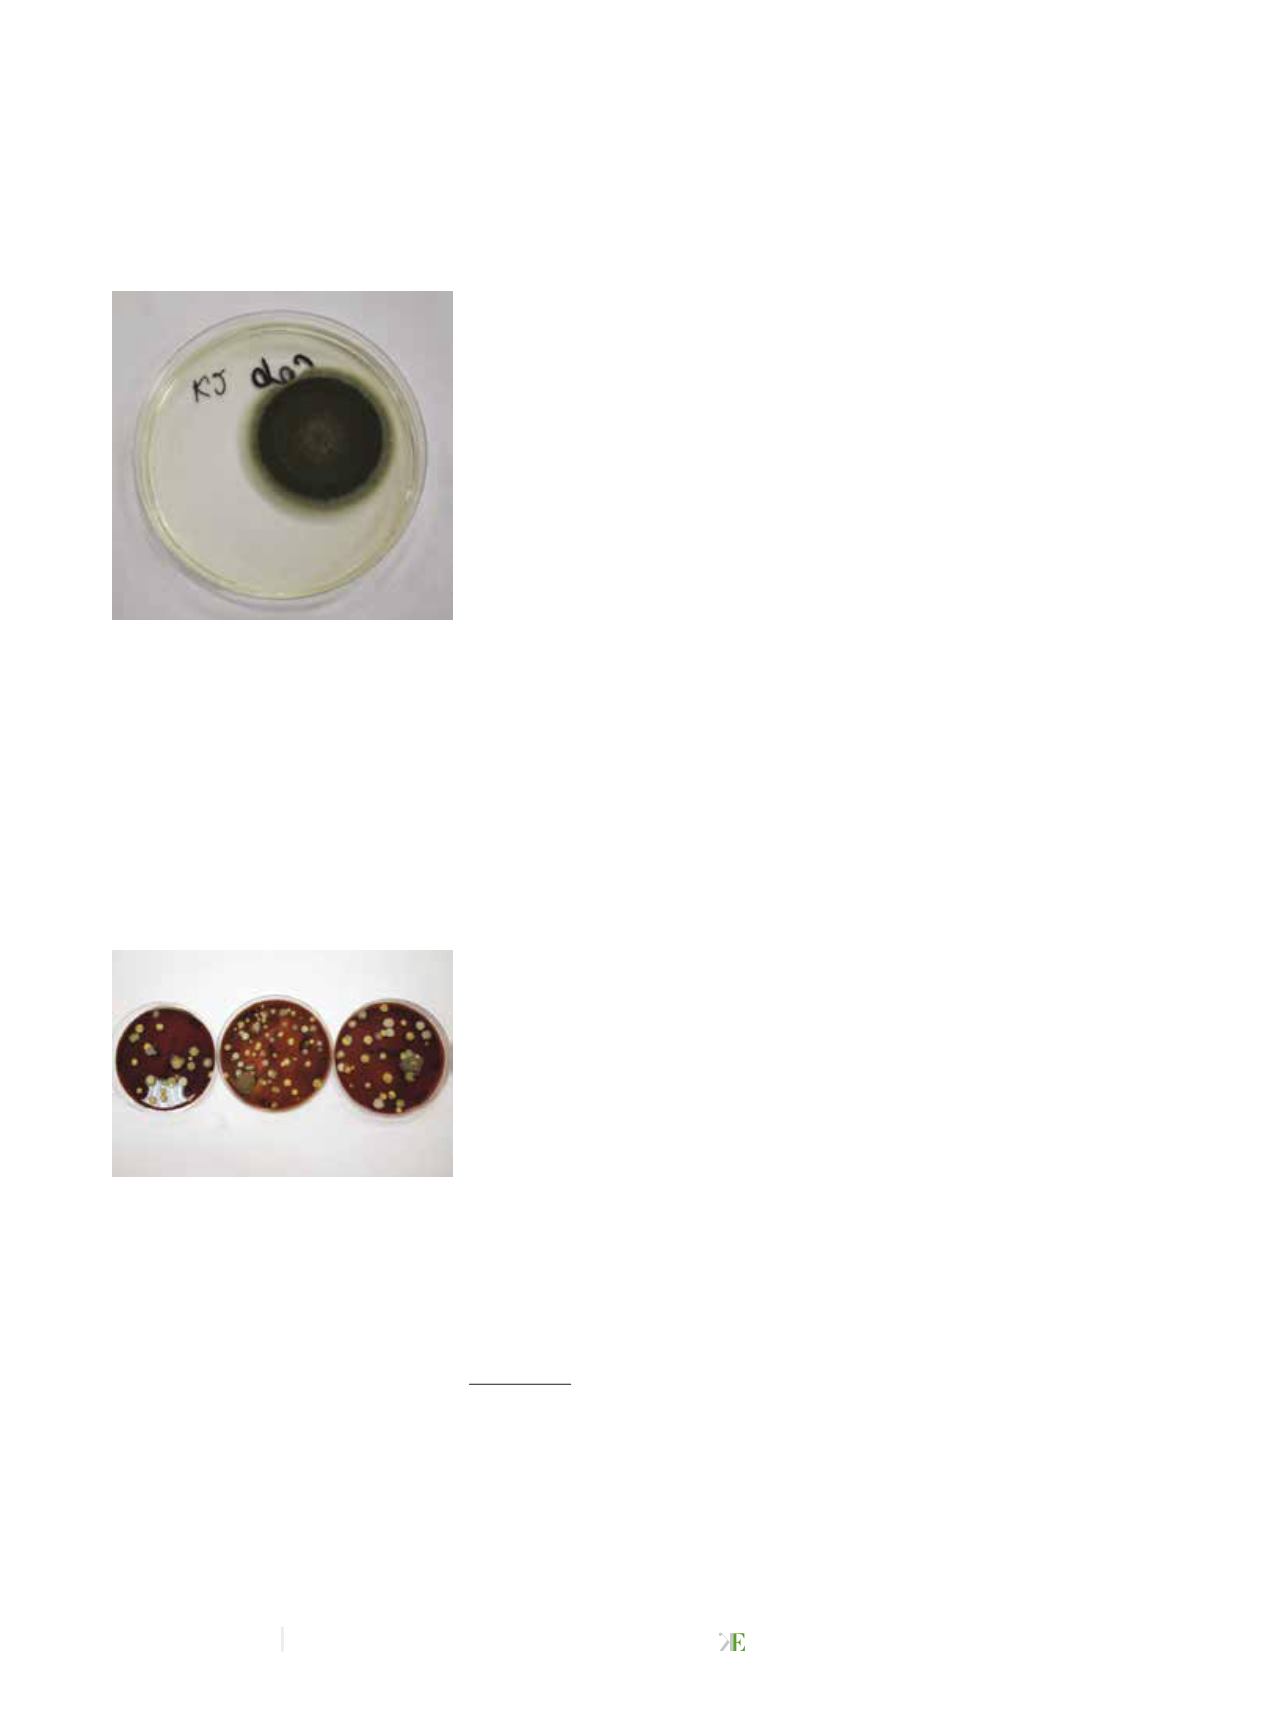

1 / 2015 / vol. 4
Kosmetologia Estetyczna
100
N
artykuł naukowy
HIGIENA I DEZYNFEKCJA
w pomieszczeniu zabiegowym i korytarzu należących
do Państwowej Wyższej Szkoły Zawodowej (PWSZ) im.
Angelusa Silesiusa w Wałbrzychu, w których pracow-
nicy i studenci przebywają przez wiele godzin dziennie.
Przypuszcza się, że wykonywane zabiegi (m.in. pedikur,
manikur, w których dochodzi
do usunięcia obumarłego na-
skórka, a tym samym wzboga-
cenia powietrza o dodatkowe
materiały biologiczne) mogą
wywierać wpływ na jakość
powietrza, które bezpośrednio
może oddziaływać na zdrowie
i samopoczucie osób tam pracu-
jących oraz uczących się.
|
|
MATERIAŁ I METODY
Badanie zanieczyszczenia mi-
krobiologicznego
powietrza
przeprowadzono w marcu 2014 roku na terenie bu-
dynku B PWSZ im. Angelusa Silesiusa w Wałbrzychu.
Próbki powietrza pobrano w sali dydaktycznej – zabie-
gowej – oraz na korytarzu. Pomieszczenia zaopatrzone
są w system wentylacyjny. W sali zabiegowej znajduje
się 11 stanowisk pracy oraz maszyny, przyrządy i ma-
teriaływykorzystywane przez studentówkosmetologii.
Materiał potrzebny do badań mikrobiologicznych,
tj. komórki bakterii, zarodniki grzybów znajdujące się
w powietrzu, pobierano na płytki Petriego, z odpowied-
nią pożywką, które umiesz-
czano na wysokości 1,3 m od
podłogi, w trzech punktach po-
miarowych. Wykonano trzy se-
sje pomiarowe tego samego dnia:
pierwszą w godzinach poran-
nych (bezpośrednio przed roz-
poczęciem zajęć dydaktycznych),
drugą w trakcie odbywających
się zajęć oraz trzecią pod koniec
dnia. Do poboru próbek wykorzystano metodę sedy-
mentacyjną Kocha. Na podstawie liczby wyrosłych na
płytkach kolonii można określić liczbę drobnoustrojów
w powietrzu wyrażoną jednostką jtk/m³ (
colony forming
units
), zgodnie ze wzorem [7]:
x -
a × 5 × 104
πr2 × t
gdzie:
x
- liczba mikroorganizmów w powietrzu
(w jtk/m³),
a
- liczba kolonii wyrosłych na płytce Petriego,
πr²
- pole powierzchni płytki Petriego (w cm²),
t
- czas ekspozycji (w min).
Zakres badań mikrobiologicznych obejmował ilościo-
we oznaczenie liczby: bakterii mezofilnych (bakterii sa-
profitycznych i pasożytniczych) na agarze odżywczym
i agarze krwawym, gronkowców mannitolo-dodatnich
i mannitolo-ujemnych na podłożu Chapmana, bakterii
z rodziny
Enterobacteriaceae
na podłożu MacConkeya
wyrosłych w temperaturze 37 °C po 24-48 godzinach
inkubacji, jak również oznaczenie liczby grzybów ple-
śniowych na podłożu Sabourauda z dodatkiem chlo-
ramfenikolu, wyrosłych w temperaturze 25 °C po 3-5
dniach inkubacji. Identyfikacja grzybów pleśniowych
oparta była na określeniu makromorfologii kolonii,
a także na ocenie preparatów mikroskopowych sporzą-
dzonych z losowo wybranych, dominujących kolonii.
Identyfikację grzybów pleśniowych do rodzaju przepro-
wadzono za pomocą użyciu atlasu
Food and indoor fungi
[8].
|
|
WYNIKI
Największe zanieczyszczenie bakteryjne stwierdzono
w sali zabiegowej podczas pierwszego pomiaru, gdzie
liczba jednostek formujących kolonie bakterii wynosi-
ła 943,99 jtk/m³. Najmniej jednostek określających ilość
mikroorganizmów w badanym materiale można było
zaobserwować w trakcie drugiego pomiaru na koryta-
rzu oraz w czasie trzeciego pomiaru w sali zabiegowej,
gdzie ich wartość wynosiła po 26,22 jtk/m³. Stężenie flo-
ry bakteryjnej podczas poszczególnych prób i w odpo-
wiednich pomieszczeniach przedstawiono w tabeli 1 i 2.
Dominującą grupą bakterii były bakterie Gram-do-
datnie, które w obrazie mikroskopowym określone
zostały jako formy kuliste układające się w grona, pa-
kietowce, dwoinki i tetrady. Z grupy bakterii Gram-
-ujemnych wyizolowano zaledwie dwa szczepy z pró-
bek pobranych z korytarza. Na podłożu agarowym
z krwią stwierdzono także występowanie silnie zazna-
czonej strefy hemolizy.
Wyizolowano łącznie 4 gatunki grzybów, z których
dominującym był rodzaj
Cladosporium
, stanowiący 60%
wszystkich wyrosłych grzybów. Stwierdzono także
obecność grzybów z gatunku
Aspergillus
,
Penicillium
oraz
Mycelia Sterilia
. Stężenie flory grzybowej wahało
się w zakresie 26,22-524,44 jtk/m³ (Fot. 1).
Większy wzrost i różnorodność grzybów zaobserwo-
wano na płytkach pochodzących z korytarza – wyłącz-
nie z tego pomieszczeniawyodrębniono rodzaj
Penicillium
.
|
|
DYSKUSJA
Według norm opracowanych przez Zespół Ekspertów
ds. Czynników Biologicznych Międzyresortowej Komi-
sji ds. Najwyższych Dopuszczalnych Stężeń i Natężeń
Czynników Szkodliwych dla Zdrowia w Środowisku
Pracy (NDS i NDN) w pomieszczeniach użyteczności pu-
blicznej dopuszczalne stężenia bioaerozolu bakteryjnego
Fot. 1
Wzrost grzybów
pleśniowych na podłożu Sa-
bourauda – Cladosporium sp.
Fot. 2
Wzrost bakterii na
podłożu krwawym